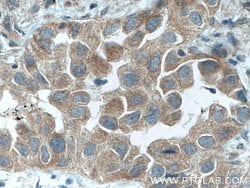
DVL2 Rabbit anti-Human, Mouse, Polyclonal, Proteintech:Antibodies:Primary

missing translation for 'onlineSavingsMsg'
Learn More
Learn More
DVL2 Rabbit anti-Human, Mouse, Polyclonal, Proteintech
Rabbit Polyclonal Antibody
£135.00 - £349.00
Specifications
| Antigen | DVL2 |
|---|---|
| Concentration | 0.41 mg/mL |
| Applications | Western Blot, Immunofluorescence, Immunohistochemistry (Paraffin), Immunocytochemistry, Immunoprecipitation |
| Classification | Polyclonal |
| Conjugate | Unconjugated |
| Product Code | Brand | Quantity | Price | Quantity & Availability | |||||
|---|---|---|---|---|---|---|---|---|---|
| Product Code | Brand | Quantity | Price | Quantity & Availability | |||||
|
16859513
|
Proteintech
12037-1-AP-20UL |
20 μL |
£135.00
20µL |
Please sign in to purchase this item. Need a web account? Register with us today! | |||||
|
16849513
|
Proteintech
12037-1-AP-150UL |
150 μL |
£349.00
150µL |
Please sign in to purchase this item. Need a web account? Register with us today! | |||||
Description
Disheveled DVL2 is a member of the dishevelled (dsh) protein family. The vertebrate dsh proteins have approximately 40% amino acid sequence similarity with Drosophila dsh. This gene encodes a 90-kD protein that undergoes posttranslational phosphorylation to form a 95-kD cytoplasmic protein, which may play a role in the signal transduction pathway mediated by multiple Wnt proteins. The mechanisms of dishevelled function in Wnt signaling are likely to be conserved among metazoans.Specifications
| DVL2 | |
| Western Blot, Immunofluorescence, Immunohistochemistry (Paraffin), Immunocytochemistry, Immunoprecipitation | |
| Unconjugated | |
| Rabbit | |
| Human, Mouse | |
| O14641, Q60838 | |
| 13543, 1856 | |
| DVL2 Fusion Protein Ag2666 | |
| Primary | |
| -20°C | |
| DVL2 |
| 0.41 mg/mL | |
| Polyclonal | |
| Liquid | |
| RUO | |
| PBS with 50% glycerol and 0.1% sodium azide; pH 7.3 | |
| Dishevelled 2, DSH homolog 2, DVL2 | |
| DVL2 | |
| IgG | |
| Antigen Affinity Chromatography | |
| Antibody |
Spot an opportunity for improvement?Share a Content Correction
Product Content Correction
Your input is important to us. Please complete this form to provide feedback related to the content on this product.
Product Title